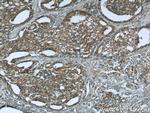
CNOT8 Antibody in Immunohistochemistry (Paraffin) (IHC (P))
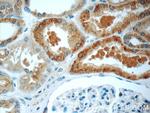
CNOT8 Antibody in Immunohistochemistry (Paraffin) (IHC (P))

Search
Proteintech
CNOT8 Polyclonal Antibody
{{$productOrderCtrl.translations['antibody.pdp.commerceCard.promotion.promotions']}}
{{$productOrderCtrl.translations['antibody.pdp.commerceCard.promotion.viewpromo']}}
{{$productOrderCtrl.translations['antibody.pdp.commerceCard.promotion.promocode']}}: {{promo.promoCode}} {{promo.promoTitle}} {{promo.promoDescription}}. {{$productOrderCtrl.translations['antibody.pdp.commerceCard.promotion.learnmore']}}
产品信息
10752-1-AP
种属反应
已发表种属
宿主/亚型
分类
类型
抗原
偶联物
形式
浓度
规格
纯化类型
保存液
内含物
保存条件
运输条件
产品详细信息
This is a rabbit polyclonal antibody raised against the full-length human CNOT8.
Immunogen sequence: MPAALVENS QVICEVWASN LEEEMRKIRE IVLSYSYIAM DTEFPGVVVR PIGEFRSSID YQYQLLRCNV DLLKIIQLGL TFTNEKGEYP SGINTWQFNF KFNLTEDMYS QDSIDLLANS GLQFQKHEEE GIDTLHFAEL LMTSGVVLCD NVKWLSFHSG YDFGYMVKLL TDSRLPEEEH EFFHILNLFF PSIYDVKYLM KSCKNLKGGL QEVADQLDLQ RIGRQHQAGS DSLLTGMAFF RMKELFFEDS IDDAKYCGRL YGLGTGVAQK QNEDVDSAQE KMSILAIINN MQQ (1-292 aa encoded by BC017366)
靶标信息
CNOT8 (CCR4-NOT transcription complex subunit 8), also known as CALIF or POP2, is a 292 amino acid protein that localizes to both the nucleus and the cytoplasm and functions as part of the CCR-NOT complex. Expressed ubiquitously, CNOT8 plays a role in transcriptional regulation for a diverse set of processes.
仅用于科研。不用于诊断过程。未经明确授权不得转售。
生物信息学
蛋白别名: CAF1-like protein; CAF1-like protein; CCR4-NOT complex subunit; Caf1b; CAF2; CALIFp; CCR4-associated factor 8; CCR4-NOT transcription complex subunit 8; h CAF1-like protein; PGK promoter directed over production; unnamed protein product
基因别名: 1500015I04Rik; 1810022F04Rik; AA536816; AU015770; AU043059; CAF1; Caf1b; CALIF; CNOT8; hCAF1; POP2
UniProt ID: (Human) Q9UFF9, (Mouse) Q9D8X5
Entrez Gene ID: (Human) 9337, (Mouse) 69125, (Rat) 363603